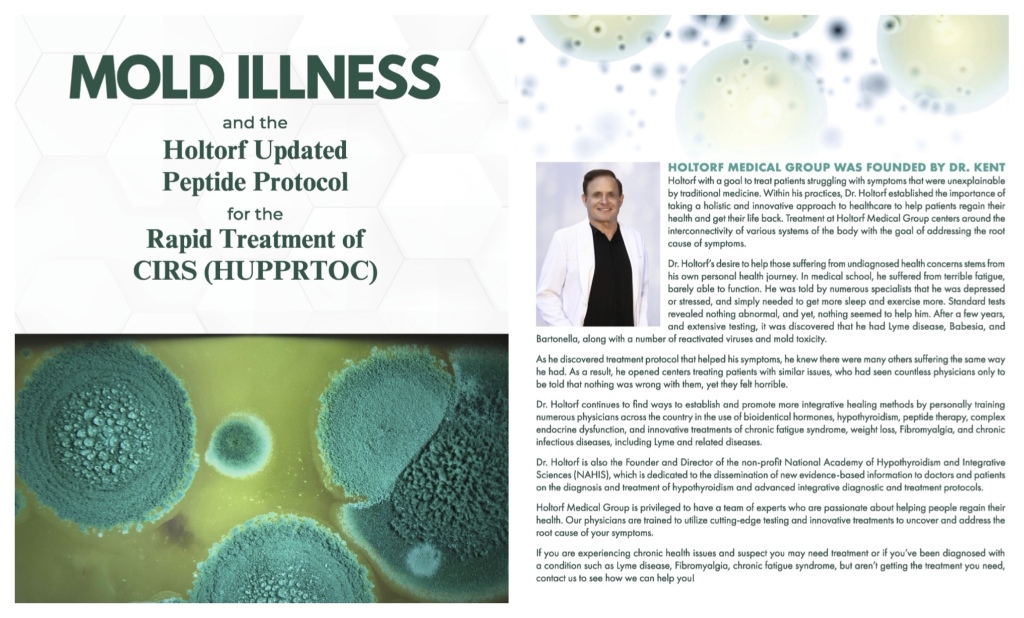

Video: https://drtalks.com/videos/holtorf-updated-peptide-protocol/
Scalability: The protocol is adaptable for many chronic illness conditions (e.g., Lyme, long COVID, autoimmunity) due to shared immune pathophysiology.
•••
This protocol leverages Dr. Holtorf’s insights to create a comprehensive, peptide-centric approach to CIRS, prioritizing immune modulation and cellular health over symptom-focused treatments like binders or VIP.
Click here to skip down to the protocol itself.
Summary:
Dr. Kent Holtorf discusses a novel approach to treating Chronic Inflammatory Response Syndrome (CIRS) and mold-associated illnesses, emphasizing immune dysfunction as the core pathophysiology underlying CIRS, Lyme disease, chronic fatigue syndrome (CFS), fibromyalgia, autoimmunity, and other inflammatory conditions.
He critiques the conventional Shoemaker protocol, which relies heavily on binders and vasoactive intestinal peptide (VIP), arguing that binders are marginally effective and fail to address upstream issues.
While VIP may provide short-term relief, it has long-term adverse effects, including immune suppression and increased cancer risk.
Instead, Holtorf advocates for his Holtorf Updated Peptide Protocol for the Rapid Treatment of CIRS (HUPPRTOC), which prioritizes immune modulation using peptides to correct immune imbalances (e.g., Th1/Th2/Th17 shifts, natural killer cell dysfunction, T cell exhaustion, and immunosenescence).
This approach enhances detoxification, mitochondrial function, and gene regulation, offering a safer and more effective treatment for mold and other complex illnesses.
He also highlights the role of hypercoagulability in chronic illness and suggests peptides and other therapies to address it.
Outline of Dr. Holtorf’s Interview
1. Introduction
• Overview of CIRS and mold-associated illnesses.
• Common immune dysfunction as the underlying cause of multiple chronic conditions.
• Critique of the Shoemaker protocol (binders and VIP).
2. Pathophysiology of CIRS and Related Conditions
• Immune dysfunction: Th1 suppression, Th2/Th17 dominance, natural killer cell dysfunction, T cell exhaustion, immunosenescence.
• Multifactorial triggers: mold, Lyme, stress, EMFs, toxins, aging.
• Vicious cycle: infections, mitochondrial dysfunction, hormonal imbalances, and coagulation issues perpetuate disease.
3. Limitations of Conventional Treatments
• Binders: Inefficient as treatment and do not address cellular detoxification or upstream immune issues. Use for detox is ok.
• VIP: Short-term symptom relief but suppresses Th1, increases cancer risk, and hinders long-term recovery.
• Genetic predisposition to mold illness is overstated; immune dysfunction is the primary driver.
4. Holtorf Updated Peptide Protocol (HUPPRTOC)
Core Principle: Immune modulation to restore balance and enhance detoxification.
Key Peptides (see below for dosing and purchasing info):
• Thymic peptides (Thymogen A1): Boost Th1, regulate immune genes, reduce POTS and inflammation.
• TB4 fragments: (TB4 Frag): Tissue healing, Anti-inflammatory, immune-modulatory, moderately helps with mast cell stimulation.
• KPV: Potent anti-inflammatory, antimicrobial, mast cell stabilizer (rated 9.5/10 for mast cell activation – MCAS).
• BPC-157: Supports gut health, reduces inflammation, stable orally if acetylated. Not advised for patients with MCAS.
• SS-31: Improves mitochondrial function, protects against toxins. Alternatively, use NAD+
• PinealPep: Anti-aging, resets hormonal and mitochondrial function, protects against mycotoxins. Not for children.
• GHK-Cu: Anti-inflammatory, potential for broader use.
5. Other Therapies:
• Heparin: Addresses hypercoagulability to improve nutrient/oxygen delivery.
• Ozone, stem cells, T3 (Thyroid Support): Support immune and mitochondrial function.
• Senolytics (e.g., Dasatinib, Fisetin): Clear senescent cells to reduce inflammation.
6. Testing and Diagnosis
Challenges with lab tests (e.g., inaccurate reference ranges for natural killer cell function).
Recommended tests:
• Natural killer cell function (Quest/Labcorp, but often unreliable).
• C4a, transforming growth factor beta (TGF-β) for Th2 dominance.
• Cyrex T cell immunity tests.
• Infectolab T cell tests for Lyme and co-infections.
• D-dimer for hypercoagulability.
• Clinical assumption: Most CIRS patients have immune activation of coagulation.
7. Additional Considerations
• Mitochondrial dysfunction is universal in chronic illness; a peptide like SS-31 or NAD+ address it.
• Emotional stress and environmental factors (e.g., EMFs, electric cars) exacerbate immune dysfunction.
• Anti-aging parallels: Immune modulation for CIRS applies to longevity and weight loss (e.g., GLP-1 peptides).
8. Conclusion
• Peptides are safe, effective, and transformative for treating complex illnesses.
• Upstream immune modulation is the foundation for recovery, replacing outdated protocols.
Goals of the Protocol
This protocol focuses on immune modulation, mitochondrial support, detoxification, and addressing hypercoagulability, while avoiding binders and VIP.
1. Restore Immune Balance: Correct Th1/Th2/Th17 imbalances, enhance natural killer cell function, reverse T cell exhaustion, and reduce immunosenescence.
2. Enhance Detoxification: Support cellular detoxification by improving mitochondrial function and reducing inflammation.
3. Address Hypercoagulability: Improve blood flow, oxygen delivery, and nutrient uptake.
4. Mitigate Mast Cell Activation and POTS: Stabilize mast cells and reduce autonomic dysfunction.
5. Protect Against Toxins: Use peptides to neutralize mycotoxin effects and prevent further damage.
Note: This is a hypothetical protocol and should be customized by a healthcare provider.
Peptide dosing will vary by patient needs.
CIRS / Mold Illness Peptide Protocol
• To Purchase – Available at Integrative Peptides except where noted. See this page: https://diaryofrecovery.com/buy
• Discount code: SAVE10 for 10% off at Integrative Peptides
1. Thymic Peptides (Immune Modulation)
• Peptide: Thymogen Alpha-1 (contains Vilon)
• Purpose: Upregulate immune genes (~450 genes), boost Th1, reduce POTS, and counteract immunosenescence.
• Dosing: Orally 5 days/week for 4–8 weeks.
• Cycle: 4–8 weeks on, 2–4 weeks off, repeat as needed based on symptoms and lab markers (e.g., natural killer cell function, C4a).
• Rationale: Thymic peptides are safe, reduce inflammation, and address the root immune dysfunction in CIRS. Vilon has shown benefits for POTS.
My thoughts: We use only 1/6-1/4 cap at a time, and dose it several times per day, sublingual.
In our group we find that some people can only use TA1 when they have an acute illlness (and need an immune boost).
Taken when they feel healthy, it brings a return of their autoimmune symptoms.
To better tolerate it I wrote a post about the HUSH blend including Thymogen
2. TB4 Fragments (Healing tissues, Anti-Inflammatory and Immune Modulation)
• Peptide: TB4-Frag
• Purpose: Reduce TGF-β, modulate immunity, avoid mast cell stimulation.
• Dosing: Orally, 5 days/week for 4–8 weeks.
• Cycle: Same as thymic peptide.
• Rationale: More targeted than full TB4, avoiding pro-inflammatory domains.
My thoughts: We like TB4 Frag for all types of tissue healing and recommend it! We use smaller doses, only about 1/2 cap per day, divided. More could likely be used without issue.
3. KPV (Anti-Inflammatory and Mast Cell Stabilization)
• Peptide: KPV
• Purpose: Potent anti-inflammatory, antifungal, antimicrobial, stabilizes mast cells (rated 9.5/10), reduces CIRS symptoms.
• Dosing: Orally, daily for 4–8 weeks.
• Cycle: Continuous use may be tolerated due to safety profile; reassess after 8 weeks.
• Rationale: KPV is ideal for mast cell activation and systemic inflammation, with broad antimicrobial and antifungal effects.
My thoughts: KPV is undoubtedly our favorite peptide! We’ve had tremendous success but we take it only in microdoses.
A lot of people who are sensitive and concerned about die off benefit from microdosing and you can read about it in our post: KPV Short Guide to healing. It also contains information for dealing with die off.
4. BPC-157 (Gut Health and Inflammation)
• Peptide: Acetylated BPC-157
• Purpose: Supports gut barrier, reduces inflammation, aids detoxification.
• Dosing: orally daily for 4–8 weeks.
• Cycle: Continuous use may be tolerated; reassess after 8 weeks.
• Rationale: Orally bioavailable of acetylated, supports gut health critical for detoxification and immune function.
My Thoughts: Because BPC 157 is often not advised for patients with mast cell activation, we don’t use it. People in our group have reported flares of MCAS or anxiety / mood issues. If you’re not in this subset, it can likely work well!
5. SS-31 (Mitochondrial Support)
• Peptide: SS-31 / alternatively, NAD+*
SS-31 is available from Limitless, see this page.
• Purpose: Improves mitochondrial function, protects against mycotoxin-induced oxidative stress, reduces fatigue.
• Dosing: 5–10 mg/day SC, daily for 4–8 weeks.
• Cycle: 4–8 weeks on, 2–4 weeks off.
• Rationale: Mitochondrial dysfunction is universal in CIRS; critical to enhance cellular energy and detoxification.
My thoughts: We prefer NAD+ to support mitochondria. We like that it can be dosed sublingually too. For NAD+ dosing see this post!
6. PinealPep (Anti-Aging and Mycotoxin Protection)
• Peptide: PinealPep
• Purpose: Resets hormonal function, protects against mycotoxins, reverses mitochondrial dysfunction. Not for children.
• Dosing: Orally, 5 days/week for 4 weeks.
• Cycle: 4 weeks on, 4 weeks off, repeat as needed.
• Rationale: Anti-aging effects translate to CIRS treatment by supporting systemic resilience.
My Thoughts: PinealPep is amazing! If you need a version without the added Thymus bioregulators you can look to endoluten or epithalon. All three versions are mentioned in this post: Our review of 40 Peptides.
Pineal Gland bioregulators are not for people who haven’t gone through puberty yet, there are concerns about the hormone modulation and anti aging – similar to concerns for taking melatonin.
7. GHK (Optional Anti-Inflammatory)
• Peptide: GHK-Cu
Available from Limitless, see this page.
• Purpose: Reduces inflammation, potential for broader use in CIRS.
• Dosing: 1–2 mg/day SC or transdermal (if bioavailability confirmed), daily for 4–8 weeks.
• Cycle: Reassess after 8 weeks.
• Rationale: Emerging as an anti-inflammatory peptide; may complement KPV and TB4-Frag.
My Thoughts: I’ve only used it topically so I can’t weigh in. A group member let us know that injections sting very badly and will leave a welt. Limitless also sells it in Capsules.
Adjunctive Therapies (Optional)
1. Heparin (Hypercoagulability)
• Purpose: Breaks down fibrin deposits, improves oxygen/nutrient delivery.
• Dosing: Low-dose heparin (e.g., 5,000–10,000 units/day SC, titrated by provider).
• Monitoring: D-dimer, fibrinogen, pulse oximetry (Holtorf’s “party test” for coagulation).
• Rationale: Hypercoagulability is prevalent in CIRS; heparin enhances treatment efficacy.
2. Ozone Therapy
• Purpose: Immune modulation, antimicrobial, improves oxygenation.
• Dosing: Per provider (e.g., 10-pass ozone or rectal insufflation, 1–2 times/week).
• Rationale: Complements peptides by supporting immune and mitochondrial function.
3. T3 (Thyroid Support) or ThyroPep
• Purpose: Addresses mitochondrial-driven thyroid dysfunction.
• Dosing: Low-dose T3 (e.g., 5–25 mcg/day, titrated by provider).
ThyroPep: Orally, see bottle – available from Integrative Peptides
• Monitoring: Free T3, reverse T3, symptoms.
• Rationale: Improves energy and cellular function.
My Thoughts: Absolutely a fan of ThyroPep, see my review here. It improves energy, body temperature regulation, reduced brain fog and more. I use 1 cap per day, in the morning.
4. Senolytics
• Agents: Fisetin or Dasatinib (under supervision).
• Purpose: Clears senescent cells to reduce inflammation.
• Dosing: E.g., Fisetin 500–1000 mg/day for 3 days, repeat monthly.
• Rationale: Supports immune modulation by removing dysfunctional cells.
My Thoughts: I’ve been taking Fisetin for a while now and love it – many describe it as feeling like you have fewer tabs open in your brain, so it definitely works! I use Dr’s Best Brand, from Amazon – 100 mg per day in the AM.
I’ve heard you can either take it low dose daily or a higher dose weekly / monthly
Lifestyle and Environmental Interventions
• Sauna and Cold Plunge: Enhance detoxification (Holtorf suggests minimal binders like charcoal or modified citrus pectin post-sauna).
• Stress Management: Stellate ganglion block or other interventions for emotional stress.
• EMF Reduction: Turn off Wi-Fi at night, avoid electric cars if palpitations occur.
• Diet: Anti-inflammatory, low-mold diet (e.g., avoid sushi unless taking minimal binders).
My Thoughts: A big YES Nervous System work / Brain rewiring. People who use Primal Trust can often feel better even before leaving their Mold environment.
See their free e book here. It’s almost enough to get you on your way without the program if you’re dedicated to learning more, but the program itself is great!
We also have a video on this topic: Nervous System Vacation
Monitoring and Testing
• Baseline Tests:
• Natural killer cell function (interpret with caution due to lab variability).
• C4a, TGF-β (Th2 markers).
• D-dimer, fibrinogen (coagulation).
• Cyrex T cell immunity panel.
• Infectolab T cell tests (if co-infections suspected).
• Follow-Up: Reassess every 4–8 weeks based on symptoms, lab markers, and pulse oximetry (coagulation status).
• Genomic Testing: Consider genie test for inflammatory gene expression (optional).
Expected Outcomes
• Short-Term (4–8 weeks): Reduced fatigue, improved POTS/mast cell symptoms, better mental clarity.
• Long-Term (3–6 months): Enhanced detoxification, reduced mold sensitivity, normalized immune markers.
• Maintenance: Periodic peptide cycles (e.g., thymic peptides every 3–6 months), ongoing lifestyle support.
Cautions
• Peptide Sourcing: Use reputable suppliers (e.g., integrative peptides mentioned by Dr. Holtorf).
See this page for links to purchase: https://diaryofrecovery.com/buy
• Provider Oversight: Dosing and combinations must be tailored to individual needs.
• Contraindications: Avoid VIP due to long-term risks; monitor for herxheimer reactions with peptides.
• Regulatory Issues: Peptide availability varies by region (e.g., restrictions in California).
Additional Notes
• Why Avoid Binders? Dr. Holtorf argues binders are inefficient because they only address toxins in the blood, not cells, and fail to fix mitochondrial dysfunction, which is critical for detoxification.
Minimal use (e.g., charcoal post-sauna or for KPV related die off) is acceptable but not central.
• Why Avoid VIP? VIP suppresses Th1, increases cancer risk, and exacerbates inflammation in the presence of TGF-β, making it unsuitable for long-term CIRS treatment.
• Future Directions: Intravenous peptides and senolytics may enhance outcomes; ongoing research into nano-KPV and other fragments is promising.
• Recap: This protocol leverages Dr. Holtorf’s insights to create a comprehensive, peptide-centric approach to CIRS, prioritizing immune modulation and cellular health over symptom-focused treatments like binders or VIP.
Always consult a healthcare provider before implementing a protocol.
Similarities / Differences to our Complex illness protocol
You will find some similarities in Dr. Holthorf’s protocol to our Protocol for PANS, Long Covid and Complex Illness.
The main differences are that ours is gentler (lower doses and fewer peptides) and geared more toward people who are sensitive or younger.
You can read about it here: Https://diaryofrecovery.com/pans
You can also download a pdf with clickable links:
And – Here’s a screenshot:

Additional Thoughts
It’s so critical that all of these treatments land on a body with a calm nervous system, especially when you have a chronic illness or mold intolerance.
Please see our post: 7 easy hacks to a calmer nervous system
And check out the free ebook from Primal Trust too (link is at the above page) 🍃
For more Peptide content from us:
Https://diaryofrecovery.com/resources


